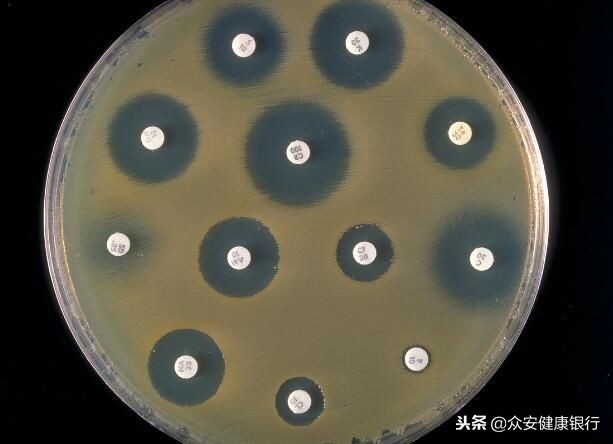
细菌性感冒服用抗生素几天见效,细菌性感染抗生素的使用原则

当你发生了感染感觉很糟糕,去看医生后医生会给你开具抗生素的处方,当你开始服用抗生素后就想知道什么时候感觉能好一些,而这或许很难预测,因为每一种感染都是不同的,因为细菌的组合、感染类型、机体的免疫反应以及服用抗生素的时间点都会有所不同,这就会影响患者恢复的时间。

图片来源:iran-daily.com
选择最合适的抗生素
抗生素只能用来治疗由细菌引起的感染(并非病毒或真菌),如今医生能够正确评估机体所患的疾病是否是因细菌感染所致,而当发生细菌性感染时,利用抗生素进行治疗或许能够有益于患者的康复,但抗生素似乎不太可能对某些疾病有效,比如并不复杂的急性中耳炎、急性细菌性鼻窦炎等。
并不是每一种抗生素能够应对每一种感染,诸如大环内酯类和喹诺酮类等广谱抗生素能够有效针对多种类型细菌感染所诱发的疾病,而窄谱抗生素则仅能有效治疗某些细菌性感染,比如青霉素类(苄青霉素)通常用来治疗肺炎链球菌引发的感染,其对治疗其它细菌引发的感染似乎效果有限。
即使抗生素曾经对一种特定的细菌感染有效,但如今其或许可能并不再能有效发挥作用了,因为细菌可能已经对这种抗生素产生耐药性了,比如过去研究人员只需要利用一种抗生素治疗淋病,但如今由于抗生素耐药性的出现,研究者就需要用两种类型的抗生素联合治疗,细菌对抗生素耐药性的产生是人类当前面临的一个非常严峻的健康问题。
那么临床医生如何选择一种最适合你的抗生素呢?抗生素疗法的选择是研究者根据多种信息的组合来决定的,包括患者自身、感染的性质、诱发感染的细菌种类以及所选择的抗生素抵御细菌的活性程度等。但识别细菌并评估抗生素抵御细菌的活性往往需要进行大量的实验室测试,这个过程可能需要2-4天,因此如果一个感染的患者寻求医生帮助的话,这或许并没有多大帮助;当然研究人员还需要开发更快的测试技术,截止到目前为止,还没有人能够在第一时间确定感染的细菌类型,并在第一次见到医生时就被开具正确的抗生素来治疗。
而在实践中我们常常接受的是经过良好教育的最佳猜测疗法,在评估一个人的疾病是否需要抗生素治疗后,在没有得到任何实验室检测结果的情况下,医生常常就能开发最佳的抗生素治疗方案,临床医生会根据患者的表现和症状、自身的专业知识来进行相应的判断。

图片来源:2011.igem.org
那么我什么时候能感觉好一点呢?
因此,如果你确定感染了某种致病菌的话,医生就会给让你服用抗生素进行治疗,那么很多人肯定会问,我什么时候能感觉好点呢?抗生素疗法的目的就是有效杀灭诱发疾病的细菌,抗生素要么会杀灭细菌,要么会阻断其繁殖,但这时就不一定会杀死细菌了,不管怎样,从你服用抗生素那一刻起,抗生素就开始在机体中发挥作用了,其会开始阻断或减缓细菌的繁殖。
相比其它细菌而言,某些细菌可能受到的影响较小,而且可能需要较长的时间才能被抗生素所杀灭或抑制,诸如铜绿假单胞菌所诱发的感染非常难以治疗,而且即使使用了最合适的抗生素,该菌所诱发的感染也会对抗生素疗法反应较慢,每一种让你患病的细菌都会给机体带来不适的感觉,机体中致病菌的水平越少,你就会感觉越来越好。
但是身体的不适并不仅仅是因为细菌感染,当遭遇感染时,机体会通过诱发免疫反应来应对细菌感染,不管是针对致病菌还是被致病菌破坏的组织(或者两者兼而有之),所有这些反应都会让你感觉到不舒服。即使抗生素开始对细菌发起攻击效应,机体也必须即使清理感染后的残留物质,免疫系统能帮助清除机体发生感染过程中所产生的碎片和损伤,包括受损的细菌菌体和组织碎片等。
当机体的免疫系统开始承担清理工作时,机体也需要修复在感染过程中所遭受的损伤,因此总体的效应就是,即使你开始服用抗生素,机体的感染症状正在消失时,你可能还是会感觉到疲倦,而且在一段时间内通常会感觉到不适。
图片来源:en.wikipedia.org
感觉糟糕
也许,比你开始感觉好一些更加重要的是,如果感觉更糟了该怎么办?根据一个人感染的严重性,如果你在服用抗生素的一两天后感觉更糟,或者担心出现一些新的疾病症状的话,你或许应该及时就医。如果你使用的抗生素是正确的抗生素,或者你需要另外一种抗生素的话,医生会从就诊过程中看到相关的信息,并根据实验室的检测结果来判断此前的诊断是否准确,以及开具的抗生素是否最合适。


参考资料:
【1】Schilder AG, Chonmaitree T, Cripps AW, et al. Otitis media. Nat Rev Dis Primers. 2016 Sep 8;2:16063. doi: 10.1038/nrdp.2016.63.
【2】Laura M. King, MPH1; Guillermo V. Sanchez, PA-C, MPH1; Monina Bartoces, PhD1; et al Antibiotic Therapy Duration in US Adults With Sinusitis, JAMA Intern Med. 2018;178(7):992-994. doi:10.1001/jamainternmed.2018.0407
【3】Morten Lindbaek. Broad-spectrum antibiotics gave no clinical benefit and more adverse effects than narrow-spectrum antibiotics in treating acute respiratory tract infections in US children, BMJ (2018) doi:10.1136/bmjebm-2018-110938
【4】Benzylpenicillin
【5】Gonorrhea Treatment and Care
【6】About Antimicrobial Resistance
【7】Smieszek T, Pouwels KB, Dolk FCK,et al. Potential for reducing inappropriate antibiotic prescribing in English primary care. J Antimicrob Chemother. 2018 Feb 1;73(suppl_2):ii36-ii43. doi: 10.1093/jac/dkx500.
【8】Jac-HoonSong. Introduction: the goals of antimicrobial therapy, International Journal of Infectious Diseases, March 2003, doi:10.1016/S1201-9712(03)90064-6
【9】Peter Ankomah, Bruce R. Levin. Exploring the collaboration between antibiotics andthe immune response in the treatment of acute, self-limiting infections, PNAS (2014) doi:10.1073/pnas.1400352111
【10】Fleming-Dutra KE, Hersh AL, Shapiro DJ, et al. Prevalence of Inappropriate Antibiotic Prescriptions Among US Ambulatory Care Visits, 2010-2011. JAMA. 2016 May 3;315(17):1864-73. doi: 10.1001/jama.2016.4151.
【11】Health Check: I’m taking antibiotics – when will they start working?
December 3, 2018 2.00pm EST, Christine Carson & Tim Inglis.